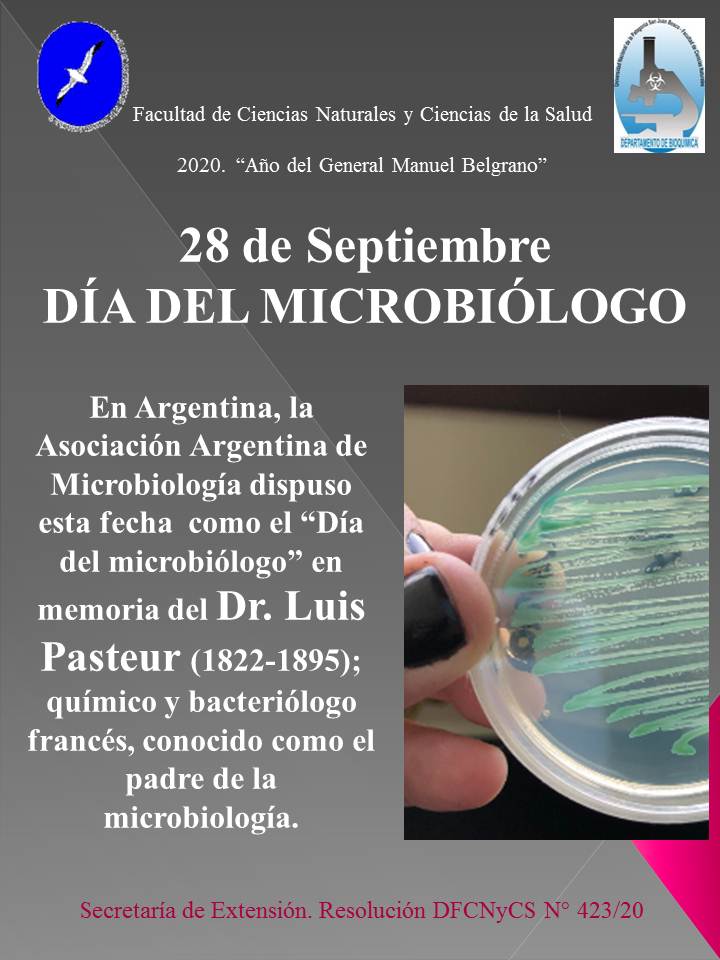

Uni
SIU- Guaraní
ROQUE ERNESTO SILVA (Q.E.P.D.)

Compartimos una noticia triste. Falleció el esposo de nuestra compañera, Susana Risso. Lo lamentamos mucho. Desde el equipo de gestión de la Facultad, la abrazamos con todo nuestro cariño.
ROQUE ERNESTO SILVA (Q.E.P.D.)
Falleció el 15/10/2020, a los 60 años. El Equipo de Gestión de la Facultad de Ciencias Naturales y Ciencias de la Salud de la UNPSJB, acompaña a la Secretaria de Posgrado, Dra. Susana Risso rogando porque encuentre pronto consuelo y resignación.
Curso de factores humanos y gestión de la seguridad en eventos críticos
Descargar información del curso
Plan detectar. Barrio Standard Norte.
Estudiantes de nuestra Facultad asumiendo un rol protagónico en el actual contexto sanitario. Los presentamos en acción..
Conversatorio Becas EVC 2020
Para estudiantes avanzados, importancia y dudas. Documentación disponible:
https://drive.google.com/drive/folders/1s7Ucyolx9dJQsQHZBU58YE8Uu0SoKeE2
Hablemos del consumo de dióxido de cloro
Actividad de Extensión: "Acompañando a la comunidad - Voluntariado del colectivo de Farmacia"
(Res DFCNyCS N°145 y 409/20).
La iniciativa está relacionada al cuidado de la salud en tiempos de COVID-19.
La coordinación estuvo a cargo de la Dra. María Luján Flores y de Dra. Graciela Pinto Vitorino.
Propuesta de Creación del Centro de interpretación del Mar Golfo San Jorge
Avalamos la presentación del proyecto de trabajo en conformación denominado: “Propuesta de Creación del Centro del Mar Golfo San Jorge”.
La finalidad del encuentro es dar a conocer la iniciativa y promover la participación de las/os docentes y alumnas/os de la facultad.
R.DFCNyCS Nro. 414/20
Efectos adversos del consumo de dióxido de cloro y productos afines
Los invitamos a participar de la disertación que ofrecerá la Dra. Graciela Pinto Vitorino el próximo viernes, quien fue convocada por la Facultad de Ciencias Exactas y Naturales de la Universidad de Belgrano.
Su exposición estará disponible en el enlace que pueden encontrar en el afiche, con inscripción a la dirección de correo del Dr. Bacelo que figura allí. 
Aval por R.DFCNyCS Nº 405/20
Día de la Sanidad
En el Día de la Sanidad, los trabajadores de la salud piden la ayuda de todos para que no colapse el sistema. Con motivo de su día, reivindicamos su vocación y apelamos a la responsabilidad y solidaridad colectiva, para evitar más contagios y honrar su compromiso con todos nosotros.
El equipo de gestión de la Facultad de Ciencias Naturales y Ciencias de la Salud adhiere a la Declaración de apoyo al personal de salud que los jefes del departamento comparten.
Cátedra Biología para Medicina: Cursada en contra cuatrimestre
Información para Estudiantes interesados
Buscar en el sitio
Ficha de inscripción para ejercer la docencia
Horarios de cursado
Requisitos para la tramitación del Título
Correos electrónicos de los docentes de la FCNyCS
Listado de direcciones de correo electrínico de los docentes para realizar consultas durante el periodo de cuarentena:
Mesas de examen
Revista Naturalia

Sede Esquel
Estamos actualizando la web. Pronto estará disponible.

Sede Puerto Madryn
Estamos actualizando la web. Pronto estará disponible.